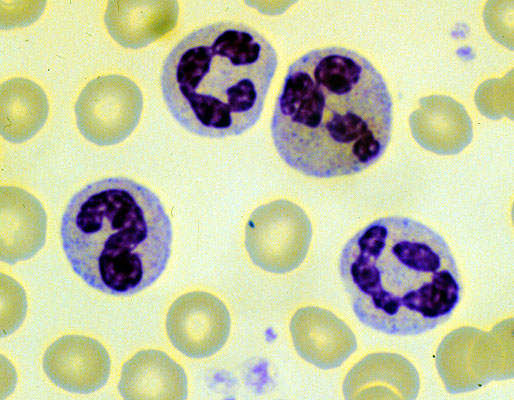

Normal neutrophils, peripheral blood smear.
Click picture to enlarge. Close window to return
Three segmented polymorphonulear leukocytes are present ("segs; poly's). These cells usually have 3-4 lobes and represent mature granulocytes. A neutrophilic band is present, which shows a non-segmented nucleus, and represents a slightly immature granulocyte.